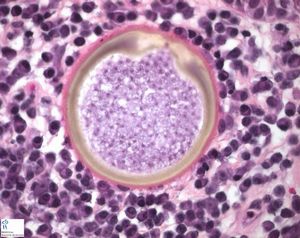

馬のピチオーシスは、沼地の癌としても知られており、熱帯または亜熱帯地域に生息する馬に多く見られる致命的となりうる病気です。
この病気は、水性真菌の一種であるピシウム・インシディオスム(Pythium insidiosum)を含む水源と直接接触することで発症します。
ピチオーシスは、米国南東部の湿地帯に生息する馬、犬、さらに程度は少ないですが猫やヒトにも頻繁に見られ、この病気が「沼地の癌」というニックネームで呼ばれるようになったのはそのためです。
馬のピチオーシスは、皮膚、胃腸、鼻顔面の3つの異なる形態で発症します。
皮膚型の疾患は、一般的に皮膚の外層に大きな潰瘍性、増殖性、化膿性肉芽腫性病変を発症します。病変は馬の脚、腹、顔に沿って最も一般的に見られますが、これらの部位は水源と直接接触した可能性が最も高いです。
皮膚のピチオーシスは一般的に治癒しない軽微な創傷から始まり、肉芽組織や壊死細胞の形成へと進み、黄色から灰色のクレーターやサンゴ様構造へと変化していきます。
ピシウム・インシディオスム(P.insidiosum)が発見された場所
ピシウム・インシディオスム:P.insidiosumは暖かい淀んだ水に生息する日和見病原体で、通常は雨季に最も多く発生します。
馬のピチオーシスのほとんどの症例は、馬の放牧地の沼地や湿地にさらされた場合、特に洪水や水の氾濫が起こった場合に関連しています。
馬のピチオーシスの診断方法
馬のピチオーシスは、細胞学的または病理組織学的検査で微生物の形態学的特徴を検出することで診断されます。
馬のピチオーシスの治療法の選択肢
治療には、病変の創面切除、創傷管理、局所創傷被覆の塗布、馬のピチオーシス免疫療法ワクチンの投与などが含まれます。
馬のピチオーシスの治療は、感染後15日以内に診断して治療を開始するのが最も効果的です。P.insidiosumは真菌に似た性質を持っていますが、抗真菌薬は有効な治療法ではありません。
症状
●手足や腹側の腹部に沿った病変、夏創(Summer sores)のただれのように見えることもあります。
●痒み
診断
●病歴
●臨床兆候
●身体診察
●細胞学
●病理組織学的検査
治療
※デブリードマン
感染した組織を外科的に取り除く。
※免疫療法
P.insidiosumの外抗原と細胞質を免疫療法的に注射する。ある研究では、この治療法が皮下のピチオーシスの馬で72%の成功率を示しました。
予後
早期に発見されない限り、予後は悪い。